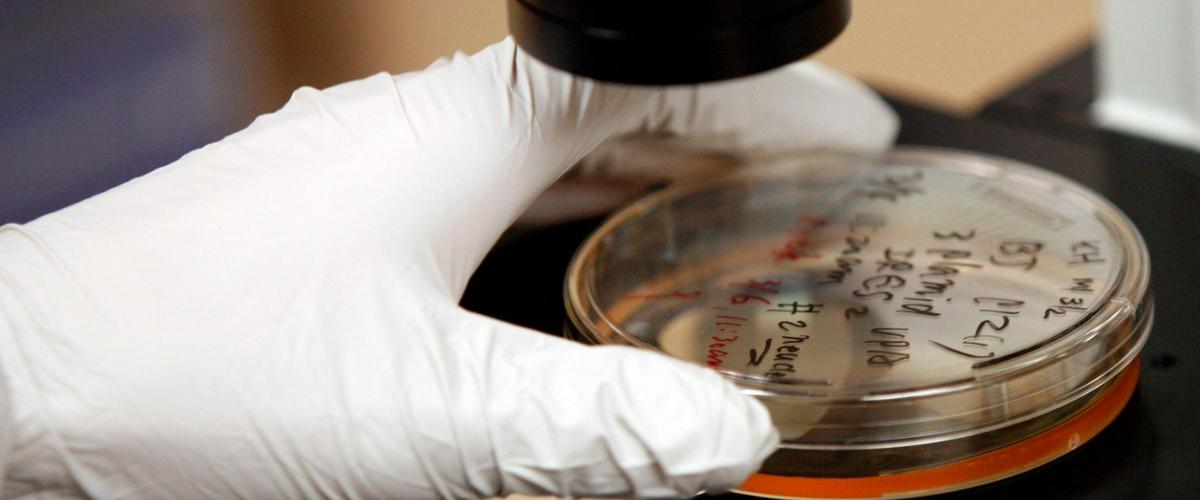
TODO:

Синтетические антитела под общим названием FLAg созданы таким образом, чтобы имитировать ключевые факторы роста — белки Wnt. В организме Wnt-белки отвечают за превращение стволовых клеток в предшественников клеток любого типа. И теперь ученым из Торонтского университета удалось использовать Wnt в качестве инструмента для активации регенерации тканей.
Эксперименты показали, что при добавлении антител в клеточную культуру они заменили белки Wnt и стимулировали образование органоида кишечника — миниатюрного прототипа органа.
Введенные антитела активировали стволовые клетки кишечника, что доказывает их стабильность и функциональность внутри организма, подчеркивают авторы. Это означает, что потенциально антитела могут быть использованы для лечения синдрома раздраженного кишечника и других заболеваний, которые провоцируют поражение слизистой.
Другие варианты антител показали многообещающие результаты в регенерации легких, печени, костей, а также продемонстрировали потенциал для лечения заболеваний глаз.
В своем стартапе AntlerA ученые уже привлекли инвестиции для преобразования антител в лекарственные средства для лечения заболеваний кишечника и болезней, провоцирующих потерю зрения.
К настоящему моменту ученые добились значительных результатов в регенерации клеток, отвечающих за слух, а также обнаружили плацентарные стволовые клетки, которые могут восстанавливать сердце и другие органы.